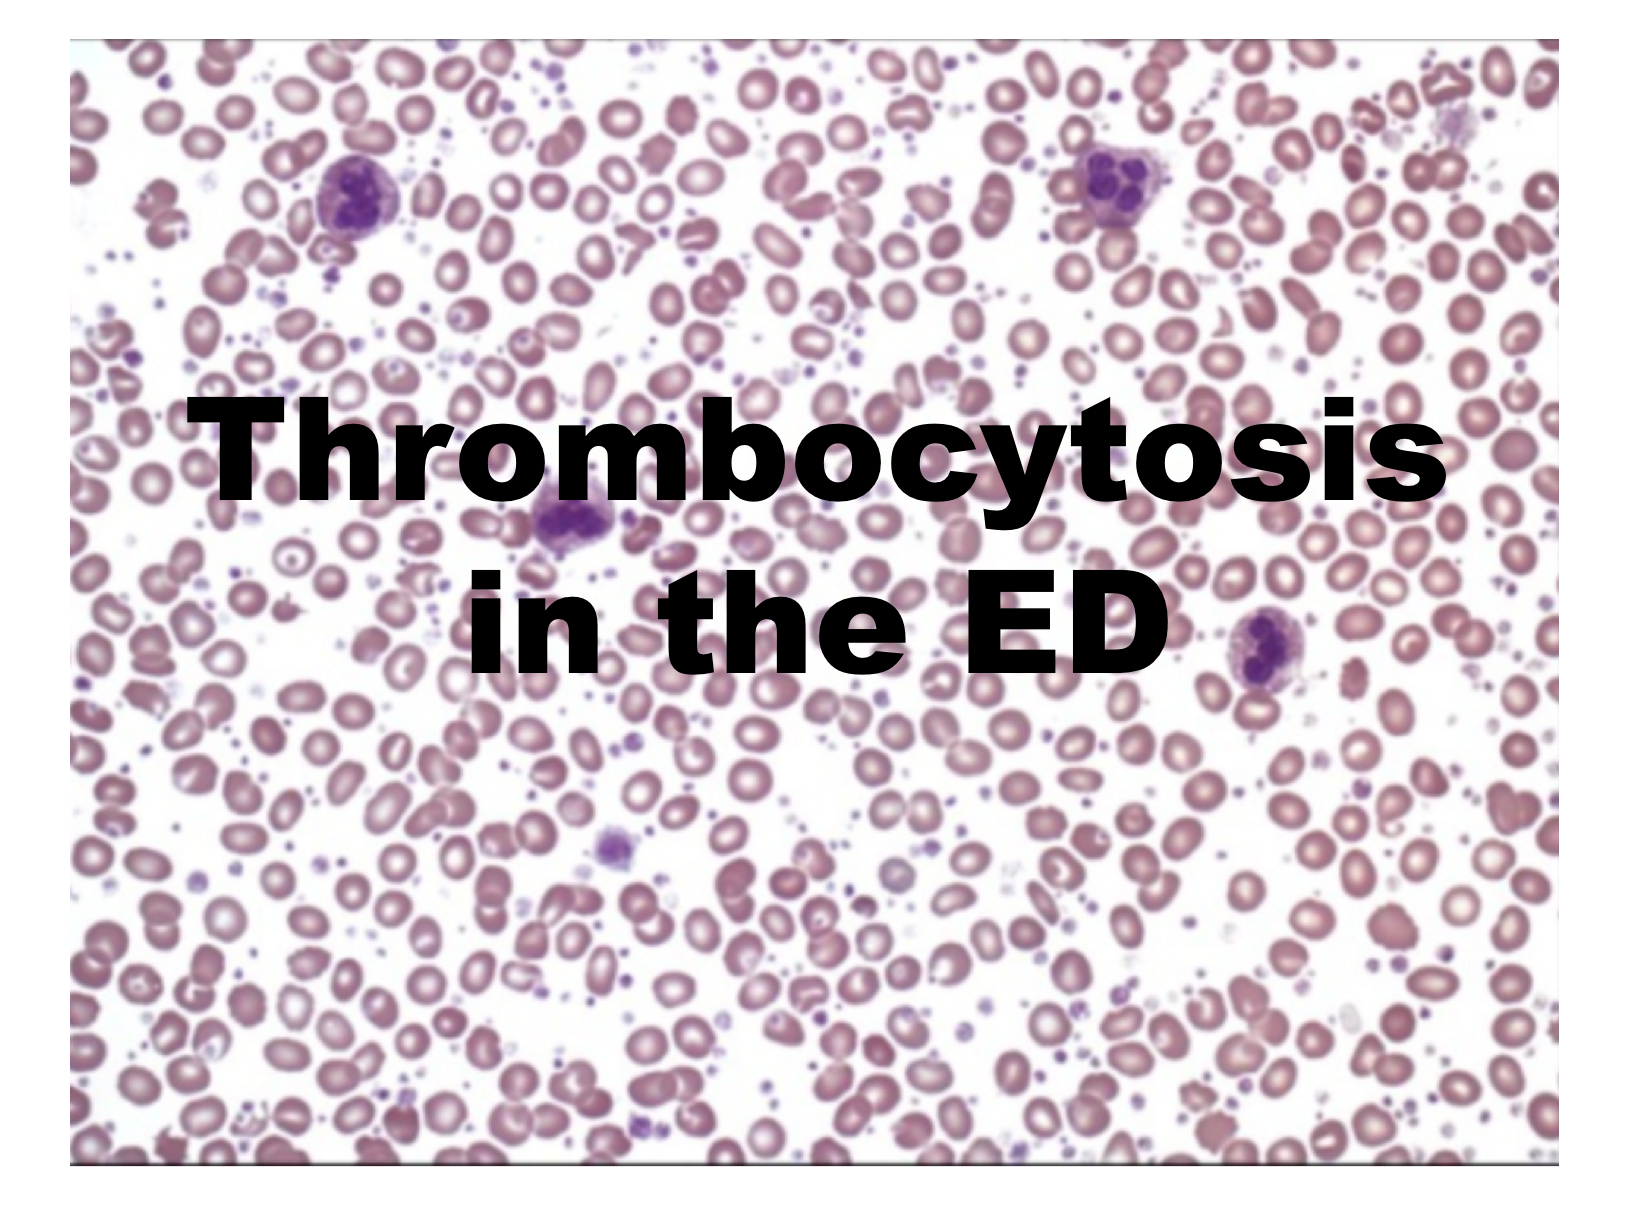

Болезнь тромбоцитоз
Болезнь тромбоцитоз 110 фото
Карола 2013
Можно ли прекратить пить антибиотики
Петербург глазами инженера экскурсии
Brawl stars 20 обновление
Ребенок не сидит массаж
Сколько будет в рублях usdt
Судебный участок 90 омск
Гражданство турции документы
Пр2 5п2нв содержание драгметаллов
Песни привет 1 час